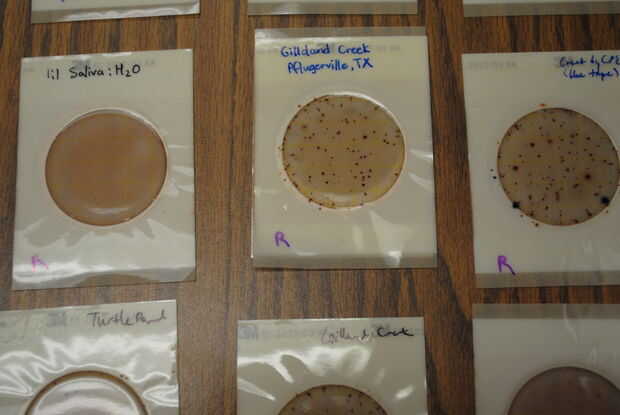

Paso 12: Inocular petrifilms y prueba
Ahora que han construido la incubadora de Petrifilm™, usted debe probar en un entorno controlado antes de confiar en él en el campo.
Recomendamos que usted obtenga la E. Coli Petrifilms™ de 3 M y y establecer un control con agua estéril. Además, pruebe el agua de un arroyo real probablemente contaminados con materia fecal. Cualquier arroyo de lento funcionamiento donde personas caminan a sus perros sin limpiar es un objetivo probable.
Siga las instrucciones de 3M para la inoculación. Esperamos hacer un separado instructable sobre este paso y el uso de la Petrifilm™ en general, pero este es un resumen.
- Ponga las películas sobre una superficie plana, con las apertura hacia las aletas.
- Llenar una pipeta de 1mL con el agua a testar.
- Levante la tapa de la primera película y utilice una pipeta para distribuir suavemente la solución en la película. Asegúrese de que la pipeta no rayar la superficie de la película, y que el agua desborde área circular de la película.
- Vuelva a colocar la hoja transparente sobre la superficie de la película. Asegúrese de que no hay burbujas de aire significativo entre la hoja y la superficie de la película.
- Utilice un marcador permanente para escribir el nombre de la muestra en cada película.
- Repita los pasos 2-5 en tantas películas como sea necesario.
- Si usted está usando más de 20 películas, usar el divisor de cartón para separar las películas primeras 20 de las películas adicionales dentro de la incubadora.
- Asegúrese de que está cargada la batería de la incubadora. Incubar las películas durante 48 horas. Garantizar la que temperatura de la incubadora no sea inferior a 37±1 ° C.
Este vídeo instruccional por 3 M puede aclarar los pasos anteriores.
Para más detalles sobre incubación de Petrifilm™, vea la hoja de datos de 3 M Petrifilm™.
Revise el termómetro varias veces durante el período de incubación para ver que está muy cerca de 37 ° C o 98 ° F. Después de 48 horas, retire el Petrifilms™. Si tiene colonias en el agua estéril o si tienes no hay colonias en el agua de la quebrada sucia, usted debe investigar más hasta entender por qué la incubadora no dio tanto un resultado negativo y positivo.
Si sin embargo usted entiende los resultados y pensar en la incubadora de Petrifilm™ está listo para uso, entonces ¡ Felicidades! Ahora tienes una incubadora de batería portátil, que puede dar información útil sin energía eléctrica disponible.
Es importante asegurarse de que tiene una carga completa de la batería. Cuando no esté en uso, desconecte el cargador y asegúrese de que está en la posición de apagado. A pesar de estas precauciones, las baterías pierden energía continuamente y es importante cargarlo antes de embarcarse en su viaje y, si es posible, antes de dirigirse al campo. Probablemente será dado de alta una batería completamente cargada a la izquierda por un mes!
Si la temperatura es muy baja, mantener la incubadora en un lugar cálido para batería vida dura a través de un período de incubación completo.